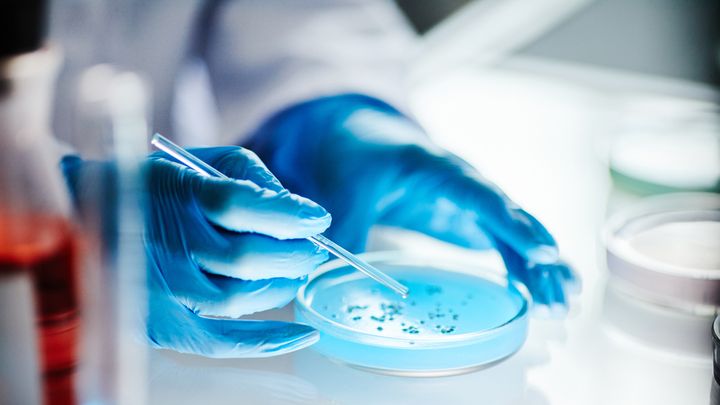
Malattia carnivora, negli Usa raddoppia l’incidenza dell’infezione che può causarla

[ad_1] Un ampio studio condotto negli Stati Uniti riporta un deciso aumento nell’incidenza dell’infezione invasiva da streptococco A, che può portare allo sviluppo della cosiddetta “malattia carnivora”. La ricerca è stata pubblicata su Jama e ha riguardato più di 20mila…
Un ampio studio condotto negli Stati Uniti riporta un deciso aumento nell’incidenza dell’infezione invasiva da streptococco A, che può portare allo sviluppo della cosiddetta “malattia carnivora”. La ricerca è stata pubblicata su Jama e ha riguardato più di 20mila casi rilevati fra il 2013 e il 2022 in dieci stati federali. In questo arco di tempo, l’incidenza sarebbe più che raddoppiata, passando da 3,6 a 8,2 casi ogni 100mila persone. Vediamo i dettagli dello studio e quali possono essere le conseguenze di questo tipo di infezione.
L’infezione da streptococco A e la “malattia carnivora”
Lo streptococco A (o Gas, Group A Streptococcus) è un batterio che si trova comunemente sulla pelle e sulle mucose interne, e diventa la causa di infezioni solo in determinate circostanze, per esempio se viene a contatto con il sangue tramite una ferita, oppure nel caso di abbassamento delle difese immunitarie. L’infezione può anche essere trasmessa attraverso il contatto diretto con il muco o la saliva di individui infetti.
Come ricorda l’Istituto Superiore di Sanità, i sintomi più comuni sono febbre, mal di gola con placche, nausea, vomito, dolori articolari. Raramente l’infezione da Gas può aggravarsi nella forma cosiddetta “invasiva” (abbreviata come iGas) e portare allo sviluppo della fascite necrotizzante, anche nota come malattia carnivora, che è una grave infezione della pelle e dei tessuti sottocutanei, che può arrivare a interessare anche i muscoli. Sempre nei casi di infezione invasiva, le tossine rilasciate dal batterio possono compromettere la funzionalità di alcuni organi e portare alla sepsi o allo sviluppo della sindrome da shock tossico.
Lo studio
Tornando allo studio appena pubblicato, nel corso della ricerca sono stati identificati un totale di 21.312 casi di iGas e 1.981 decessi correlati. Come anticipato, lo studio è stato condotto fra il 2013 e il 2022 in dieci stati Usa. I più colpiti sarebbero gli over 65, anche se l’aumento relativo dell’incidenza di iGas nel corso del tempo sarebbe stato più elevato nella popolazione di età compresa fra i 18 e i 64 anni, passando (in questa specifica fascia di età) da 3,2 a 8,7 casi ogni 100mila persone.
Inoltre, secondo i risultati l’incidenza sarebbe più elevata all’interno delle popolazioni native, rispetto ad altri gruppi etnici. Anche le persone senza fissa dimora, che fanno uso di droghe o i residenti di strutture di assistenza a lungo termine sarebbero più a rischio di contrarre la forma invasiva dell’infezione da streptococco A. Infine, un altro dato che emerge dalla ricerca riguarda la resistenza dei ceppi batterici isolati nel corso dello studio ad alcuni antibiotici: quelli non sensibili ai macrolidi e alla clindamicina sarebbero aumentati dal 12,7% nel 2013 al 33,1% nel 2022.